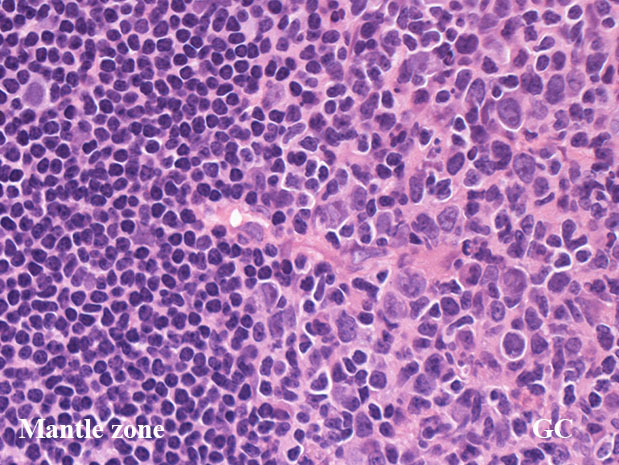

![[PukiWiki] [PukiWiki]](image/title-logo.png)
![[PukiWiki] [PukiWiki]](image/title-logo.png)
2018.1.13日 第8回リンフォマニアの会講演から
竹内賢吾先生のご講演内容の記載で一部誤りがありました。ご本人から連絡をいただき訂正いたしました. このページ, 竹内先生ご本人確認すみの内容です。
revised WHO2016 classification*1
濾胞中心follicular center(胚中心 germinal center)のB細胞から構成される腫瘍. 典型的にはcentrocyteおよびcentroblast/large transformed cellsが腫瘍の細胞成分であり, 少なくとも一部に濾胞パターンを示す.
部分的に採取された組織(sampled tissue)が完全にびまん性パターンであっても, centrocyte, centroblastから構成されるリンパ腫はFLの範疇に含む(かなり稀であるが)
自然経過において, 細胞悪性度cytological gradeが進行することはよく見られる現象であり, centroblastからなるびまん性リンパ腫はDLBCLへのprogressionの証拠になる.
4つのFL variantがある
1) in situ follicular neoplasia (以前は FL in situ)
2) dudenal-type FL
3) testicular FL
4) the diffuse variant of FL
Primary cutaneous follicle center lymphomaは別に分類される
Paediatric(米語ではPediatric)-type FLも別に分類される; FLはほぼ例外なく大人adultの疾患であり(median 60歳代), 18歳未満の乳幼児思春期には非常に、稀に、起こることがある.
18歳未満におこる節性リンパ腫 nodal lymphomaをPaediatric-type FLとする.
リンパ節の皮質cortexは, primary follicle(一次濾胞)とsecondary follicle(二次濾胞; 右図)から構成される.
primary follicle;
主にナイーブB細胞と記憶B細胞から構成され, μおよびδ重鎖とポリクローン性の軽鎖を細胞に表出させている. 形態的には小型リンパ球からなり胚中心はなく, small/ large cleaved cellは見られない.
bcl-2陽性. CD10, bcl-6は陰性. bcl-2陽性の一次濾胞をFLと間違えないよう注意.
secondary follicle;
胚中心(germinal center: GC)とmantle zoneをもつ.
mantle zoneはprimary follicle構成細胞と同じB細胞からなる. mantle zoneには厚い薄いがみられ, 薄いときはmantle zoneがないように見え, 子供のリンパ節に多い.
germinal center(GC)は, B細胞, T細胞, 抗原提示細胞, tindible-body macrophageが混在して構成されている. B細胞が優位に多く, small/ large cleaved cell(centrocytes)とlarge non-cleaved cells(centroblasts)が認められる。
正常胚中心のcentrocyte, centroblastsはbcl-2陰性であり, CD10, bcl-6が陽性となる. surface Igは低レベルであるが細胞質に通常 μ重鎖タイプ(IgM)Igが認められる.
T細胞はCD4+/ CD8-のhelper/inducer cellsであり, follicular (helper)T-cell:Tfhとよばれる. PD-1+, CXCL13+, CD57+.
抗原提示細胞の多くは follicular dendritic cellであり, 提示抗原からmyofibroblastの特殊型細胞で骨髄のstromal cell前駆細胞由来と考えられている.通常この細胞は組織学的に区別しがたいが, 微細な傾向のクロマチン, 明瞭な小型核小体をもち細胞質が不明瞭な多核細胞(Warthin-Finkeldey cell)があればfollicular dendritic cellとして区別できる.
CD21+, CD35+, CD23+とclusterin+ CD23はときに陰性のことがあるので注意.
胚中心内で, 明るい類円形の核が2つくっついている細胞はまずtindible body macrophage follicular dendritic cellでtindible body macrophageとの鑑別に有用です. (竹内賢吾Dr談)
高度に活性化された胚中心では, centrocyteとT細胞から構成される light zone (LZ)と増殖の盛んなcentroblastsとtindible-body macrophageの多いdark zone(DZ)が区分されるようになり, 極性(polarization)をもつといわれる.
ときにmantle zoneの外側にmarginal zoneが認められることがあり, 腸管膜リンパ節によく見られる.

centrocytes(左図), centroblasts(中央, 赤矢印), Mantle zone-GC boder(右図) クリックで拡大図.
centrocyteはくびれや切れ込みのある核をもつ中から大型の細胞で核小体は明瞭なものと不明瞭なものがある.
centroblastは類円形大型のvesicularな核をもったN/C比大の細胞. 核小体が複数個核辺縁にくっつくように認められる.
胚中心には核分裂像やapoptosis像が多く, 正常胚中心のMIB-1 indexは高い。(FLでは low MIB-1 indexとなる. 後述)
WHO2017 bule book Follicular lymphoma(巻頭の一覧表)
Follicular lymphoma
Paediatric-type follicular lymphoma
Large B-cell lymphoma with IRF4 rearrangement
Primary cutaneous follicle center lymphoma
Definition(定義)の本文中のFollicular lymphomaの小分類のうち diffuse variant of FL が巻頭一覧から抜けている.
FLの頻度は全リンパ腫のうち約20%, 5例に1例の割合. 1994-95年の集計では6.7%*2とされており増加傾向をしめしているようである.
Follicular lymphomaには高悪性度リンパ腫への進行, 進展がありうる. この場合, 腫瘍のびまん化だけではなくblast化の所見が重要である.
典型的な病理所見
腫瘍濾胞
Grade 1-2(low grade): 0-15 centroblast/hpf
1: 0-5 centroblast/hpf
2: 6-15 centroblast/hpf
Grade 3: >15 centroblast/hpf
3A: Centrocytes present
3B: Solid sheets of centroblasts
対物40x 18mmの視野の場合(0.159mm2),10個のhpfを数えて10で割る(。視野の広さによりcount方法が異なる。
濾胞増殖pattern
腫瘍細胞のほとんどがcentrocyteであっても右図のようにcentroblastを超えるような大型細胞が1個でもあれば,他に大型細胞のみからなる腫瘍性胚中心がないかと,より注意して観察するようにしています。
ほぼすべてがcentroblast/largetransformed cellからできあがっている腫瘍性胚中心があれば,low-grade componentだけではなく,high-grade component(grade 3B)が存在するという診断になります (Dr竹内賢吾談--許可を得て先生の文章をそのままパクり)
低倍率像で濾胞は濾胞間組織にくらべ明るくみえる症例がほとんど。これは小型リンパ球よりやや大型で蒼白な腫瘍細胞が増殖するため。
濾胞が濾胞間組織より暗く見えるreverse patternの症例が認められる。
腫瘍性濾胞は均等にリンパ節全体に分布する。辺縁洞は閉塞され,時に被膜外へ浸潤する。
FLの骨髄浸潤
Follicular lymphoma*4
血液病理の誤解に「濾胞内増殖細胞がBcl2陰性ならばfolliculr lymphomaは否定できる」、がある。 真実は「それは間違い。FL grade1/2の10%はBcl2陰性を示す*5。そのほかの検査で正しく診断すること!」
FLの特徴的な形態像*6
1. 腫瘍性胚中心の外にも腫瘍細胞が存在する.--胚中心外にCD10陽性細胞が多数いれば腫瘍を考える.
2. Paratrabecular(傍骨梁)型の骨髄浸潤像を示すリンパ腫はまず, FLを考える. 穿刺吸引では腫瘍細胞がとれてこない場合がよくある.
3. FLは血管侵襲像が多く認められるリンパ腫である. (特異度感度は高くないが教科書的にも書かれている)
4. 印鑑細胞が認められるリンパ腫はFLないし, そのtransformationをまず考える.--t(14;18)があるのではないかと考える.
5. Marginal zone differentiationがある.
BCL2免疫染色陰性FLのBcl2遺伝子はsomatic hypermutationのために変異している可能性がある.
抗体によっては変異したタンパク質をepitopeとしてとらえられず陰性となるBCL2 pseudo-negativeがありえる。(図 )*4
HEで増殖する濾胞がFLのパターン, 免染でCD20+, CD10陽性細胞が濾胞外にこぼれる所見(これは異常な所見!!)があればBcl2陰性であっても, FLを考えて核型の確認「t(14;18)(q32;q21)」, FISHでのBcl2/IGHを確認することが必要
t(14;18)(q32;q21.3)/ bcl2/IgH rearrangementをもつ典型的なFL症例を示す.
本例のような典型例がFLの70%を占め, 30%は生物学的特性の異なる非典型例といえる*7
IWT case 66y.o male
鼠径部リンパ節腫大に気づく. 近医でPETの精査をうけ, 頚部, 縦隔, 腋窩, 鼠径などほぼ全身のリンパ節に腫大が認められた.当院を紹介され受診.鼠径部リンパ節を生検する.
HE所見: サムネイル画像をクリックすると大きな画像がみられます.
| File not found: FL_loupe_s.jpg | File not found: FL_follicle-mpf01_s.jpg | File not found: FL_folliclehpf01_s.jpg |
| loupe像 | x40 | x400,増殖細胞はcentrocytes優位 |
免疫染色
| File not found: FL_CD20_s.jpg | File not found: FL_BCL2_s.jpg | File not found: FL_CD10_s.jpg | File not found: FL_BCL6_s.jpg |
| CD20 | BCL2 | CD10 | BCL6 |
MIB-1(Ki67)-indexが低い濾胞は異常. CD10陽性細胞が濾胞辺縁や濾胞間にも見られるのは異常である---FL診断の重要な「必ずあってほしい~あってほしい所見」
| File not found: FL_MIB1_s.jpg | File not found: FL_CD10-lpf_s.jpg | File not found: FL_t14-18_s.jpg |
| MIB-1 index; low | 濾胞外にCD10+細胞がこぼれている | 核型はt(14;18)の単独異常 |
CD10陰性follicular lymphoma
- CD10陰性のFLサブセットが存在し, このようなFLでは,IRF4/MUM1が陽性となる*8
- CD10陰性FLサブセットの典型的例では, bcl2転座を欠くが, bcl6の増幅は認められる.
- CD10陰性FLサブセットは高齢者に多くみられ, grade3A, 3BのFL.
- IRF4/MUM1再構成をもつDLBCLは部分的にfollicular patternの増殖を呈し, 鑑別が必要になる.
FLは骨髄中前駆B細胞の段階で 18q21.3に局在しミトコンドリアの膜安定に寄与するBcl-2をコードするBCL2遺伝子がIGHと染色体転座[t(14;18)(q32;q21.3)]に伴って結合することから発生する.
Green MR, et al.(右図)*11
FLのdiagnosis/ relaps時においてexome sequencingにより, 3段階の変異モデルが考えられる.
これらの解析により, 腫瘍再発にかかわる細胞は腫瘍細胞のうちのminor populationであることが推察されている.
CREBBP
(CREB binding protein: NCBI Gene ID:1387)
BCL6, TP53のアセチル化も行うヒストンアセチル化酵素(HAT)蛋白をコードする. この遺伝子変異はFL症例の32%に認められる.*13
Bcl6は標的遺伝子の転写を負に制御するリプレッサーとして機能する.BCL6の機能が低下すると負の制御が効かなくなる.
DLBCLの39%, FLの41%に遺伝子欠損および/または体細胞変異がおこり, CREBBPおよびEP300, 2つの遺伝子のHAT coding domainが除去/不活性化されている. この異常は片側アレルにおこりHAT量の減少がリンパ腫発生に重要なことを示唆している.
アセチル化によりもたらされるBCL6 oncoproteinの不活性化とp53の腫瘍発生抑制がこの遺伝子異常により機能しなくなることが示された.(Pascallucci, et al.)*14
変異はCREBBPのHAT domainに集中しており, Bcl6遺伝子発現が変化することがCREBBPが関与するFLの発生機転と推察される.
BCL6 oncogeneの活性変化をきたすCREBBP遺伝子の変異部位が集中していることから, FLの治療標的にあげられている. *15
1. BCL2-negative follicular lymphoma - complex karyotypeを示したcase-->症例のページをみる
IWT-case 68歳男性 鼠径部リンパ節の腫大
2. Diffuse follicular lymphoma variant : Diffuse follicular lymphoma variantで発症, 寛解8年後にconventional type FLを再発した case--->症例ページをみる
IWT-case 84歳女性(再発時. 初発は76歳.)
3.Follicular lymphoma transformed to DLBCL
IWT-case
4.Follicular lymphoma, Grade3B
IWT-case
5.small lymphocytic follicular lymphoma,--->腹膜多発結節.
IWT-case
6.Floral variant of follicular lymphoma, CD10-negative case--->症例ページをみる
7. duodenal-type follicular lymphoma cases --->duodenal-type follicular lymphoma 十二指腸濾胞性リンパ腫
8. reverse variant of follicular lymphoma, grade3B --->reverse variant of follicular lymphoma